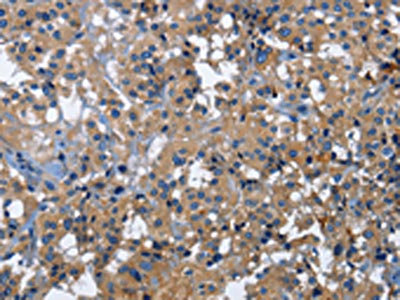

CD46 Antibody
-
中文名稱:CD46兔多克隆抗體
-
貨號:CSB-PA930156
-
規格:¥1100
-
圖片:
-
The image on the left is immunohistochemistry of paraffin-embedded Human liver cancer tissue using CSB-PA930156(CD46 Antibody) at dilution 1/30, on the right is treated with fusion protein. (Original magnification: ×200)
-
The image on the left is immunohistochemistry of paraffin-embedded Human thyroid cancer tissue using CSB-PA930156(CD46 Antibody) at dilution 1/30, on the right is treated with fusion protein. (Original magnification: ×200)
-
-
其他:
產品詳情
-
Uniprot No.:
-
基因名:
-
別名:CD46; MCP; MIC10; Membrane cofactor protein; TLX; Trophoblast leukocyte common antigen; CD antigen CD46
-
宿主:Rabbit
-
反應種屬:Human
-
免疫原:Fusion protein of Human CD46
-
免疫原種屬:Homo sapiens (Human)
-
標記方式:Non-conjugated
-
抗體亞型:IgG
-
純化方式:Antigen affinity purification
-
濃度:It differs from different batches. Please contact us to confirm it.
-
保存緩沖液:-20°C, pH7.4 PBS, 0.05% NaN3, 40% Glycerol
-
產品提供形式:Liquid
-
應用范圍:ELISA,IHC
-
推薦稀釋比:
Application Recommended Dilution ELISA 1:1000-1:2000 IHC 1:25-1:100 -
Protocols:
-
儲存條件:Upon receipt, store at -20°C or -80°C. Avoid repeated freeze.
-
貨期:Basically, we can dispatch the products out in 1-3 working days after receiving your orders. Delivery time maybe differs from different purchasing way or location, please kindly consult your local distributors for specific delivery time.
-
用途:For Research Use Only. Not for use in diagnostic or therapeutic procedures.
相關產品
靶點詳情
-
功能:Acts as a cofactor for complement factor I, a serine protease which protects autologous cells against complement-mediated injury by cleaving C3b and C4b deposited on host tissue. May be involved in the fusion of the spermatozoa with the oocyte during fertilization. Also acts as a costimulatory factor for T-cells which induces the differentiation of CD4+ into T-regulatory 1 cells. T-regulatory 1 cells suppress immune responses by secreting interleukin-10, and therefore are thought to prevent autoimmunity.; (Microbial infection) A number of viral and bacterial pathogens seem to bind MCP in order to exploit its immune regulation property and directly induce an immunosuppressive phenotype in T-cells.; (Microbial infection) Acts as a receptor for Adenovirus subgroup B2 and Ad3.; (Microbial infection) Acts as a receptor for cultured Measles virus.; (Microbial infection) Acts as a receptor for Herpesvirus 6/HHV-6.; (Microbial infection) May act as a receptor for pathogenic bacteria Neisseria and Streptococcus pyogenes.
-
基因功能參考文獻:
- Only type-I interferon restricts viral replication of attenuated Measles virus (MV) Schwarz strain in mice, independently of the presence of hCD46 receptor. PMID: 30199752
- CD46 levels were positive in 3.3% (n = 3) and negative in 96.7% (n = 90). Conclusion This study does not support the theory of measles virus as the cause of otosclerosis. PMID: 28971731
- Findings demonstrate that CD46 is a key inhibitor of complement activation whose downregulation may be involved in the pathogenesis of bullous pemphigoid. PMID: 28273946
- these data suggest a possible mechanism underlying the regulatory function of CD46 on T cells. PMID: 29066539
- study demonstratede that MMP-9-mediated shedding of CD46 is an integral part of autocrine Th1 regulation and that this pathway is dysregulated in T cells from patients with systemic lupus erythematosus PMID: 28444759
- the cell surface expression level of CD46 was markedly higher in patient myeloma cells with 1q gain than in those with normal 1q copy number. PMID: 27841764
- Our findings reveal a novel role of CD46 in accelerating inflammatory responses upon meningococcal infection or LPS stimulation by regulating the functional polarization and survival of macrophages. PMID: 27794168
- study reveals common CD46 and IFI44L SNPs associated with measles-specific humoral immunity, and highlights the importance of alternative splicing/virus cellular receptor isoform usage as a mechanism explaining inter-individual variation in immune response after live measles vaccine PMID: 28289848
- study showed no genotype differences in CD46 IVS1-1724 C>G Single nucleotide polymorphis (SNP) between Recurrent Spontaneous Abortion and fertile women PMID: 27921411
- Isoforms of CD46 impact on HHV-6B infection and thereby in part explain the distinct tropism of HHV-6AGS and HHV-6BPL1. PMID: 28056415
- This study suggests that the promoter polymorphism (rs2796267, -496 A/G) CD46 gene may be related to susceptibility of acute renal allograft rejection in Korean kidney transplantation recipients. PMID: 27234742
- provides insight into CD46 alternative splicing regulation with implications for its function in the immune system and for genetic disease PMID: 27226545
- CD46 controls both Th1 activation and regulation via a miR-150-dependent mechanism. PMID: 26746193
- Data show that CD28 antigen costimulation modulates CD46 antigen surface expression on activated T cells. PMID: 25787182
- This review summarizes our current knowledge of disease-associated mutations in this complement inhibitor(CD46). PMID: 26054645
- It was not discover any association between A304V or other CD46 SNPs and preeclampsia. PMID: 25710174
- gene deficiency results in defective Th1 cell induction due to failure in metabolic reprogramming PMID: 26084023
- Each mutant C3b bound MCP at reduced affinity, providing a molecular basis for its reduced cofactor activity in atypical hemolytic uremic syndrome. PMID: 25879158
- The mutations in the regulators CFH, CFI and MCP involve loss-of-function, whereas those for C3 involve gain-of-function. PMID: 25188723
- Results suggest a possible role for multidrug resistance genes ABCA10 and ABCA6 in follicular lymphoma survival and add to the evidence that genetic variation in CD46 and IL8 may have prognostic implications follicular lymphoma. PMID: 25294155
- Expression of membrane complement regulators, CD46, CD55 and CD59, in mesothelial cells of patients on peritoneal dialysis therapy. PMID: 25725314
- Functional characterization of two novel non-synonymous alterations in CD46 and a Q950H change in factor H found in atypical hemolytic uremic syndrome patients. PMID: 25733390
- Transgenic hCD46/HLA-E expression reduced humoral xenoresponses since all were downregulated during ex vivo xenoperfusion of hCD46/HLA-E double transgenic pig forelimbs with human blood. PMID: 24635052
- The expression levels of CD46, CD55, and CD59 were significantly higher in colon cancer tissues compared with the normal adjacent colon tissues. PMID: 24978917
- The present study suggests that CD46 plays an important role in hepatocellular carcinoma carcinogenesis by regulating let-7b and miR-17. PMID: 24297460
- Data show that calcitriol affects the CD46 pathway, and that it promotes anti-inflammatory responses mediated by CD46. PMID: 23144765
- We found that CD46 and CD59 were decreased in retinal pigment epithelium cells in part, by their release in exosomes and apoptotic particles. PMID: 24664706
- C3aR and CD46 activation via intrinsic generation of their respective ligands is an integral part of human Th1 (but not Th2) immunity. PMID: 24321396
- patients with MCP mutations only have a good long-term prognosis with 15% to 20% disease recurrence after KTx PMID: 24247905
- Case Report: patient with atypical haemolytic uremic syndrome with combined membrane cofactor protein CD46 and complement factor I mutations undergoing successful kidney transplantation. PMID: 23519521
- Mutations in membrane cofactor protein is associated with end-stage renal disease in a patient with hemolytic uremic syndrome caused by infections by Escherichia coli strains producing Shiga-like toxins. PMID: 23731345
- Data show that increased CD35, CD46, CD55 and CD59 on neutrophils and monocytes present potent markers of bacterial infection and viral infection. PMID: 23376460
- Thus, while nectin-4 and CD46 interact functionally with the measles virus H protein beta4-beta5 hydrophobic groove, SLAM merely covers it. PMID: 23760251
- HCV incorporates selectively CD59, but not CD46 or CD55, in its envelope to gain resistance to CML in serum of infected individuals PMID: 23049856
- Hepatitis B virus X protein protects hepatoma and hepatic cells from complement-dependent cytotoxicity by up-regulation of CD46. PMID: 23391762
- The alternative pathway of complement may play a role in the pathogenesis of HELLP syndrome. PMID: 22594569
- The aim of this study was to determine the transcript and protein levels of complement decay-accelerating factor (DAF) and membrane cofactor protein (MCP) in the placentas of women with acquired and inherited thrombophilia. PMID: 23042280
- we found that CD46 regulated the expression of Notch receptors and ligands during T cell activation and that disturbance of the CD46-Notch crosstalk impeded induction of IFN-alpha and switching to IL-10. PMID: 23086448
- Data show that mutations in CD46 and CFH did not predispose to systemic lupus erythematosus (SLE) or nephritis but was associated with earlier onset of nephritis. PMID: 22171659
- mumps virus (MuV) and vesicular stomatitis virus (VSV) assemble to include CD46 and CD55, two host cell regulators which inhibit propagation of complement pathways through distinct mechanisms. PMID: 22761385
- Prostaglandin (PG)E2 has a novel role in CD46 functions, which might at least partly explain the diverse roles of PGE2 in T cell functions. PMID: 22544928
- Three CD46 variants (rs7144, rs11118580, and rs2724384) were significantly associated with measles virus-specific IgG levels (P = 0.008, P = 0.026, and P = 0.018, respectively). PMID: 22357652
- in systemic lupus erythematosus, the expression of leukocyte MCP at the mRNA level is closely related to disease activity PMID: 22247341
- Data suggest that HBXIP upregulates CD46, CD55 and CD59 through p-ERK1/2/NF-kappaB signaling to protect breast cancer from complement-dependent cytotoxicity. PMID: 22293503
- The strongest associations replicated in both cohorts were found for four SNPs within CD46 (p-value<10(-3)) and five SNPs within CFH (p-value<5x10(-3)). PMID: 22153652
- Subjects previously immunized with measles-mumps-rubella vaccine were genotyped for 66 candidate single nucleotide polymorphisms in the CD46, SLAM and CD209 genes. PMID: 22086389
- Mutations in the MCP gene seems to be a common etiology of atypical hemolytic uremic syndrome in Czech patients PMID: 21706448
- protein expression is an unfavorable prognostic factor in breast cancer cases PMID: 21617523
- Data sshow that variants in SFTPD, CD46 and IL1R1 are associated with IPD in both EA and AA. PMID: 21858107
- the A304V mutation in the MCP gene is not strongly associated with RM or FL. PMID: 21840606
顯示更多
收起更多
-
相關疾病:Hemolytic uremic syndrome atypical 2 (AHUS2)
-
亞細胞定位:Cytoplasmic vesicle, secretory vesicle, acrosome inner membrane; Single-pass type I membrane protein. Note=Inner acrosomal membrane of spermatozoa. Internalized upon binding of Measles virus, Herpesvirus 6 or Neisseria gonorrhoeae, which results in an increased susceptibility of infected cells to complement-mediated injury. In cancer cells or cells infected by Neisseria, shedding leads to a soluble peptide.
-
組織特異性:Expressed by all cells except erythrocytes.
-
數據庫鏈接:
Most popular with customers
-
-
YWHAB Recombinant Monoclonal Antibody
Applications: ELISA, WB, IHC, IF, FC
Species Reactivity: Human, Mouse, Rat
-
Phospho-YAP1 (S127) Recombinant Monoclonal Antibody
Applications: ELISA, WB, IHC
Species Reactivity: Human
-
-
-
-
-